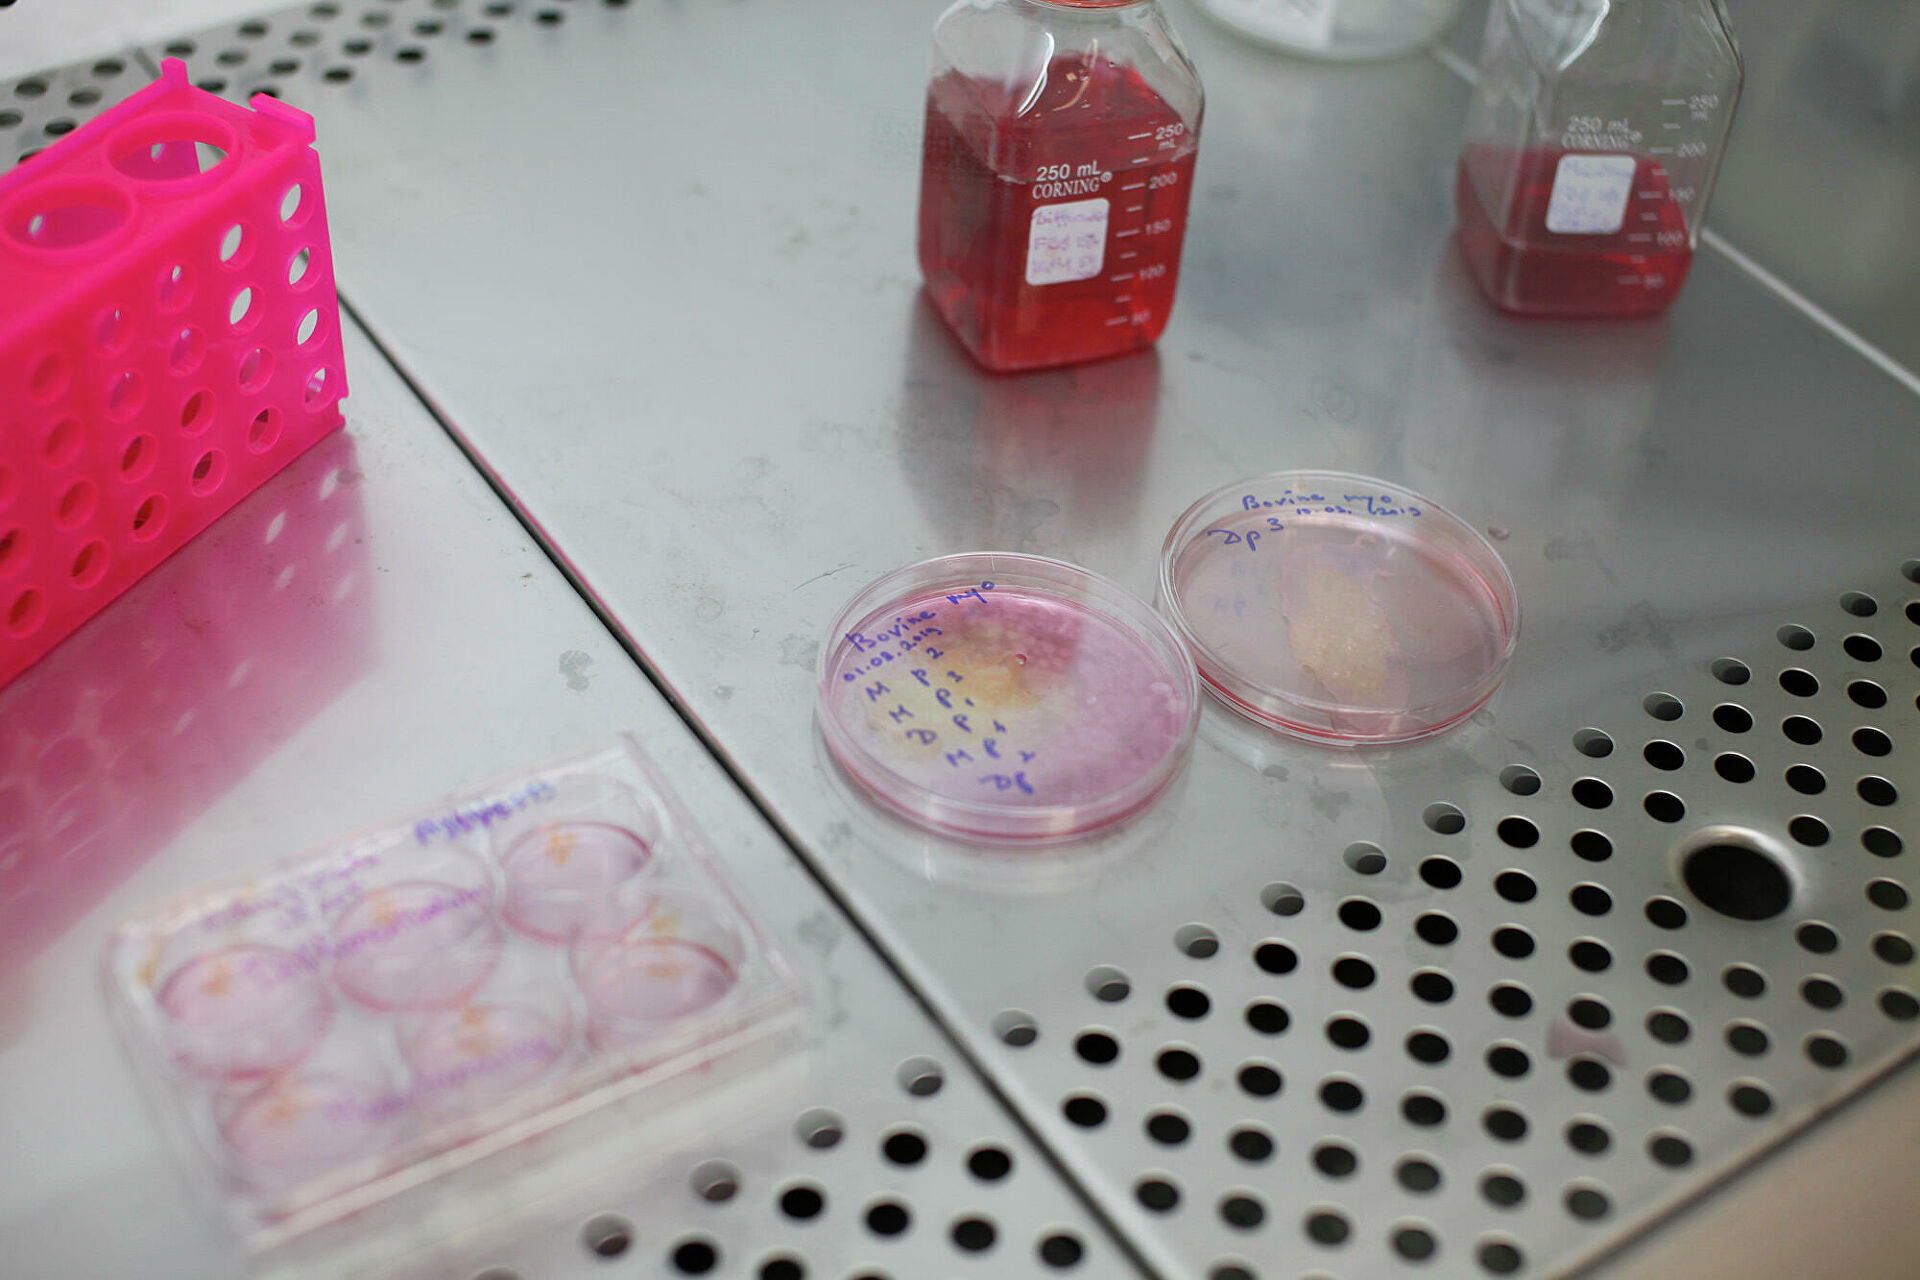
Как настоящие. На прилавках появится искусственно созданная еда Как настоящие. На прилавках появится искусственно созданная еда

Как настоящие. На прилавках появится искусственно созданная еда
/ Перейти в фотобанк

Перейти в фотобанкЧитать ria.ru в Привычные продукты очень скоро могут измениться, и люди этого даже не заметят. Уже сейчас во многих странах безопасной признана пища из мучного червя. А ученые, в том числе и российские, экспериментируют с хлебом из муки насекомых, растят мясо в пробирках и получают в лабораториях молоко, практически неотличимое от настоящего. РИА Новости разбирается, зачем это нужно и будет ли такая пища столь же полезна, как натуральная.
Начало положено
В начале года Европейское агентство по безопасности продуктов питания объявило личинок мучного червя съедобными для человека. Уже в мае это одобрили все страны ЕС. А французская компания Agronutris, подавшая официальную заявку, в течение пяти лет будет единственным поставщиком «пищевых» насекомых на рынке. Но, скорее всего, недолго: в Еврокомиссии еще 11 запросов, в частности по поводу сверчков, кузнечиков, мух черных львинок и трутней медоносной пчелы.Конечно, речь идет главным образом не о личинках как таковых, а о сделанной из них муки. Ее собираются добавлять в повседневные продукты питания, хлеб, выпечку. Как показывают эксперименты, люди охотно соглашаются попробовать блюдо с насекомыми, если они там незаметны — например, печенье с мукой из сверчков. А вот есть жареные или отварные личинки и кузнечиков мало кто готов.Продукты с мучным червем скоро появятся в большинстве крупных торговых европейских сетей. В ЕС его уже давно разводят в промышленных масштабах — для животноводческих и рыбных хозяйств. В России, как отмечает член рабочей группы дорожной карты FoodNet Национальной технологической инициативы (НТИ) Андрей Зюзин, хлебобулочные изделия из белка насекомых станут доступны в ближайшие два года. И высока вероятность, что первым одобренным пищевым насекомым окажется муха черная львинка. Во-первых, муку из нее уже производят в стране, правда, пока на корм скоту. Во-вторых, отечественные исследователи экспериментируют с этим продуктом при выпечке хлеба. В частности, сотрудники НИИ хлебопекарной промышленности недавно установили, что в тесто оптимально добавлять пять процентов муки из черной львинки. Тогда хлеб по пористости и вкусу будет не сильно отличаться от обычного, а содержание белка повысится. Как подсчитали ученые, сто граммов такой выпечки — это 13 процентов суточной потребности в белке. Однако некоторые специалисты считают этот результат завышенным. Дело в том, что часть белка входит в состав хитиновых оболочек, которые практически не перевариваются человеком.

Муха черная львинка (слева) и приготовленная из насекомых мука (справа)
Дешево и экологично
Беспозвоночными членистоногими как источником пропитания исследователи заинтересовались давно. Еще в 2013-м эксперты Продовольственной и сельскохозяйственной организации ООН предупреждали, что один из наиболее вероятных сценариев преодоления грядущего продовольственного кризиса — выращивание и употребление в пищу насекомых.С одной стороны, в них, помимо белка, много других питательных веществ — кальция, цинка и железа. С другой — насекомых намного экологичнее выращивать, чем крупный рогатый скот. Выбросы парниковых газов, связанные с культивированием личинок насекомых, почти в десять раз меньше, чем при производстве говядины (сравнение проводилось по объему выделенной углекислоты на килограмм полученного белка). А еда из насекомых вполне может считаться натуральной, в отличие от продуктов, созданных в лабораторных условиях.

Выбросы парниковых газов, связанные с культивированием личинок мучного хрущака (обозначены зеленым цветом), в сравнении с выбросами этих же газов, связанных с выращиванием домашней птицы и скота. Синим цветом обозначен минимальный уровень выбросов, красным — максимальный
Мясо из пробирки
Еще один способ решить проблему с дефицитом животного белка — вырастить искусственное мясо. Это пытаются сделать в биореакторах, чашках Петри и даже на листьях растений. Так, в об удачных экспериментах недавно отчитались сразу в Японии и Британии. В Стране восходящего солнца получили кусочек мышечной ткани коровы размером в один квадратный сантиметр и толщиной в несколько миллиметров. Мясо, внешне похожее скорее на жидкий фарш, вырастили в чашке Петри из стволовых клеток животного. Продукт британских биотехнологов тоже больше напоминал фарш, но появился он не в пробирке, а на обыкновенной траве.

10 декабря 2020, 14:05НаукаУченые назвали самый полезный способ приготовления говядиныДело в том, что некоторые растения схожи по структуре с мясными волокнами. Этим решили воспользоваться. С травы удалили собственные клетки, а оставшийся целлюлозный каркас заселили мышечными клетками свиньи. В итоге 35 процентов из них прикрепились, и вырос кусочек свинины. По вкусу он немного отличался от настоящего мяса. Для сочности надо добавлять жировые клетки и клетки соединительной ткани, уточняют авторы работы.»Большинство таких экспериментов подразумевает, что состав культивируемого мяса можно будет регулировать — в зависимости от целей определять, сколько будет белков, сколько жиров. Жир, как известно, придает определенный вкус. Но в целом об этом пока рано говорить. Сейчас все мы, по сути, растим чистый белок», — объяснил РИА Новости российский биотехнолог, генеральный директор Очаковского комбината пищевых ингредиентов (ОКПИ) Александр Савков.

11 декабря 2020, 08:00НаукаСтейк без капли крови. Создано самое чистое мясо
Котлеты за девять миллионов
Возглавляемая им лаборатория в ОКПИ — одна из немногих у нас в стране, где сумели вырастить искусственную телятину.»Мы договаривались с фермерами и крупными племенными хозяйствами. Они оперативно сообщали: родился бычок. Нам нужно было животное породистое, с хорошей родословной, не старше трех дней. Почему? В этом возрасте они очень интенсивно растут. В их биоматериале максимально много клеток, за которыми мы и охотились. Выезжали в Смоленскую, Ленинградскую и Пензенскую области. Там под местной анестезией брали биоматериал — проводили микрооперации в поле, сенях, коровнике», — рассказывает Савков.

Ученые берут биоматериал у новорожденного бычка, чтобы вырастить из него искусственное мясоБиоматериал помещали в специальную среду в чашку Петри, куда добавляли витамины, микроэлементы и ферменты для роста. Через два месяца образовывался кусочек мяса, похожий на суфле. Цена заоблачная: первые полкило — почти девять миллионов рублей. «Безусловно, очень дорого. Но основные затраты — культивируемая среда. Это медицина, а медицинские препараты сильно дорожают. Значит, надо от этого отходить. Этим сейчас и занимаемся. В остальном к нашей технологии вопросов нет. Мы пробовали созданное нами мясо, правда, в сыром виде — по вкусу очень похоже на телятину», — отметил специалист.
Чашки Петри с культурой клеток, из которого ученые растят искусственное мясо
Ни рыба ни мясо
Искусственное молоко — его получают в биореакторах с помощью дрожжей или грибов — не дороже обычного. Все полезные минералы и витамины — кальций, калий и фосфор — добавляют в нужном количестве. А вот лактозы в нем нет, и его смело могут пить люди с непереносимостью молочного сахара. Искусственные «молочные» белки, получаемые в биореакторах, годятся и для мороженого, йогурта, сыра. В США они уже признаны безопасными для питания, на очереди страны Евросоюза.

26 мая 2018, 08:00Наука»Вкусно и полезно, а холестерина нет». Почему люди едят насекомых и червейБолее того, не так давно ученые сообщили о создании аналога грудного молока. Продукт по макроэлементам не сильно отличался от натурального. При этом в нем содержались дополнительные питательные вещества.Такое молоко тоже может скоро появиться на прилавках магазинов.